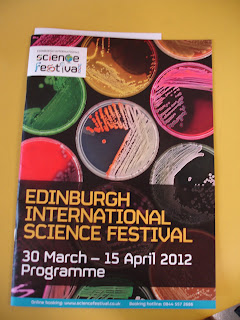

We had a brilliant time 'up north' despite the weather giving up on its two weeks of summer that led up to the Easter school break. We've seen it all. Rain, sun, snow, high winds, and everything in between. Glad we packed our winter woollies!
There was a visit to the cinema, a morning in the local swimming/wave pool. And the big day out. A day trip to Edinburgh. The original plan was to go to the zoo and see the pandas. The train was booked and paid for before we found out that visiting the pandas had to be pre-booked. And every slot for the entire two week break was already booked. Besides which the pandas had been unwell and no one had been seeing them (though this might have changed since) at all.
So what do you do when you have paid for the day out, the weather is blowing a very cold hoolie and you have two children to entertain? This is what I recommend.
 |
| A dry, boring museum. |
 |
| Only this museum is anything but dry or boring. Even the main hall from which most of the galleries led was magnificent. |
 |
| You had your usual exhibits, though brilliantly laid out... |
 |
| ... with a cheeky twist! |
 |
| I loved these prayer wheels... |
 |
| ... but must be turning into a 'proper' quilter, because I kept seeing design possibilities in the embellishments around the actual prayer wheels. |
|
| An added bonus to our visit was that it coincided with the Science Festival. |
 |
| This means we got to sign the girls up for a work shop, where they programmed robot arms. |
 |
| And I realised that their education is soooo different to the one I got, because they took to the task like fish to water! |
 |
| They also got to play Connect Four... |
 |
| ... against a robot. |
 |
| No, neither of them won. Though no one else did either according to the man running it. |
 |
| We had a brief interlude on the Royal Mile, but it was bloody cold. |
 |
| So it was inside for hot chocolates - one wearing her new souvenir Tam o' Shanter. |
 |
| And a new bear for Helen, appropriately named Scott. |
I forgot to take photos in the brilliantly good Chinese restaurant we had our dinner at before heading back to Newcastle on the train. My mum maintains that I could sniff out a Chinese restaurant anywhere, any time, with unerring accuracy. I pride myself on this fact.
More on our wee holiday tomorrow. Though less photo heavy. Seems taking a blogging break made me forget to take photos too. Though (obviously) not on our day out in Edinburgh!
Susan

Welcome home
ReplyDeleteWelcome home missus, missed you! Shame about the pandas but I used to love going to that museum when I was a kid too :-) Glad you and the girls ( & mum) still had a good day!
ReplyDeleteso glad you had a good time xx
ReplyDeleteWelcome home!!
ReplyDeleteGood to have you back Susan - the museum looks fab and love the photo of Emma and the Tam.
ReplyDeleteLooks like you had a brilliant time! Welcome home :)
ReplyDeleteSorry about the pandas, although they were too busy, *ahem* getting to know each other this week to be paying attention to much else ;o) That main hall is where the fish ponds used to be, but glad you had fun even without playing catch the fishy ;o)
ReplyDeleteGlad you had an enjoyable day out in Edinburgh - I dragged my mum into all the museums the length of the Royal Mile in my youth...would be more interested in the shopping now!
ReplyDeleteWelcome back! So pleased you enjoyed your break and Edinburgh looked like a lot of fun :)
ReplyDeletegreat photos and looks like you had a great break
ReplyDeleteWelcome Home ! Happy Easter too! I LOVE that museum, great for adults too! So much inspiration there! Looks like you had a fab time all round!
ReplyDeletePleased to hear you had a good time even though you missed seeing the pandas.
ReplyDeleteOooh! The science teacher in me loves those robots! Looks like the girls had a great time! Grand to have you back too!
ReplyDeleteNice to have you back. Thanks for bringing the delightful weather back with you x
ReplyDeleteAs you may be aware my son is at uni in Edinburgh. I was up there at the end of March and he took me to this museum. I've not blogged about it yet but I intend to, I enjoyed my visit. It is a small world!
ReplyDeleteWelcome back!
ReplyDeleteWelcome back, I know what you mean about seeing quilting patterns, I see ideas for cakes everywhere. The girls looked like they were having fun.Tell Emily I like the new haircut. It makes her look much older.
ReplyDeleteLooks like you had a fabulous time away - we are off to my parents' place at the beach for a few days !
ReplyDeleteThat museum sounds like great fun, glad to hear you had a lovely time.
ReplyDeleteGood to see you again and Happy Easter. Great to know you had a nice time despite the crazy weather.
ReplyDeleteOh how I love Edinburgh! I didn't realise you were actually visiting up here north of the border! That museum is excellent isn't it? We haven't took our kids yet but I would really love to maybe during the summer holidays now. Love your photos so much. Glad you had a great time but yep it is freezing up here! xxxxx (did you buy the obligatory Edinburgh rock?)
ReplyDeleteLooks like a great vacation!
ReplyDeleteLooks like a lovely day out!
ReplyDeleteLooks like you had an amazing time, the museum looks fab!
ReplyDeleteOoooo fun fun fun! I love science museums, they bring out the kid in me (which, to be honest, is not difficult!) x
ReplyDelete